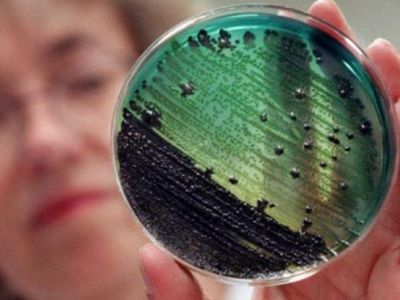
Maistinės zoonozės - Visagine

Расписание богослужений с 25 по 31 мая
31 мая - День Святой Троицы
Загрузка...
--

Премьер-министр Литвы Андрюс Кубилюс выступил в защиту уволенных руководителей Службы расследований финансовых преступлений (СРФП), сообщили в понедельник, 27 февраля, ИА ...

Jau 12 kartą žurnalo „Veidas“ sudaryta komisija išrenka Lietuvos įmonių Metų vadovą

Lietuvos statistikos departamentas prognozuoja, kad 2012 m

Achemos grupе отказывается от планов на строительство второго альтернативного газового терминала в Клайпеде, если государство готово последовательно, целенаправленно и прозрачно ...

Даугавпилсская дума планирует выделить средства на курсы латышского языка для горожан, сообщила LETA пресс-секретарь самоуправления Лига Корсак

Новый спектакль театральной студии ДДТ «Синяя птица» с аншлагами прошел в выходные на сцене зала «Орбита» ВКЦ

Франция и Великобритания договорились объединить усилия для строительства новых атомных электростанций, чтобы уже в ближайшие годы обеспечить себя самым дешёвым ...

Такой шуточной репликой Римантаса Кумписа, вызвавшей аплодисменты среди депутатов, завершилось принятие бюджета самоуправления на 2012 год на прошедшем 23 февраля ...
Zoonozė – bet kuri liga, galinti natūraliu būdu persiduoti iš gyvūnų žmogui

Сюжет о новом спектакле театральной студии ДДТ «Синяя птица» смотрите сегодня в 19.00 ч

Подготовка котлована на площадке будущей АЭС в Белоруссии начнется в июне этого года, заявил первый вице-премьер страны Владимир Семашко в ...

Глянцевый журнал «Veidas» знакомит читателей с некоторыми героями списка офицеров резерва КГБ и мнением генерального директора Центра исследований геноцида и ...

Финансово-экономический кризис в Белоруссии закончился

До 3 марта в художественной галерее Висагинской публичной библиотеки проходит первая фотовыставка Аудрюса Линге «Технологии»

За комментарий — наказание в виде 4 месяцев ограничения свободы и 30 часов работы на благо общества в доме престарелых ...

Жильцам многоквартирных домов предлагают выкупать свои тепловые пункты, чему некоторые упорно сопротивляются, пишет «Lietuvos rytas»

Бывшие акционеры литовского банка Snoras — Владимир Антонов и Раймондас Баранаускас — намерены подать в Стокгольмский арбитражный суд иск к ...


Latvijos istorikai tikisi susipažinti su archyviniais dokumentais, saugojamais Rusijos archyvuose, kurie gali būti svarbūs ir Lietuvai

Расписание богослужений в храме св.вмч.Пантелеимона с 27 февраля по 4 марта (1-я седмица великого поста) ...

В острых дискуссиях о последствиях языкового референдума в Латвии защитники двуязычия часто апеллируют к опыту других европейских стран, в которых ...

Отец основатель легендарного протокола BitTorrent Брэм Коэн анонсировал новую версию пирингового протокола, которая поддерживает потоковое вещание

Информационная служба Reuters сообщила 14 февраля 2012 года, что «рейтинговое агентство Moody’s предупредило о возможном снижении рейтинга ААА (Triple A) ...

Согласно статистике Службы охраны госграницы Литвы СОГГЛ, в этом году сохраняется прошлогодняя тенденция, когда впервые за всю историю СОГГЛ нарушающих ...

Задымление было зафиксировано минувшей ночью на 5–м энергоблоке крупнейшей в мире АЭС «Касивадзаки– Карива»

В ближайший вторник, 28 февраля, в штате Калифорния пройдет аукцион с необычными лотами — оригинальными статуэтками премии «Оскар», присужденными до ...

«Наше преимущество перед Польшей и Литвой только в одном — мы уже строим АЭС», — об этом заявил в ходе ...


Польша вопреки воле жителей страны намерена построить на своей территории атомную электростанцию

Сегодня ветеранская сборная России по хоккею обыграла сборную звезд мира в матче, посвященном 40–летию знаменитой Суперсерии 1972 года между сборными ...